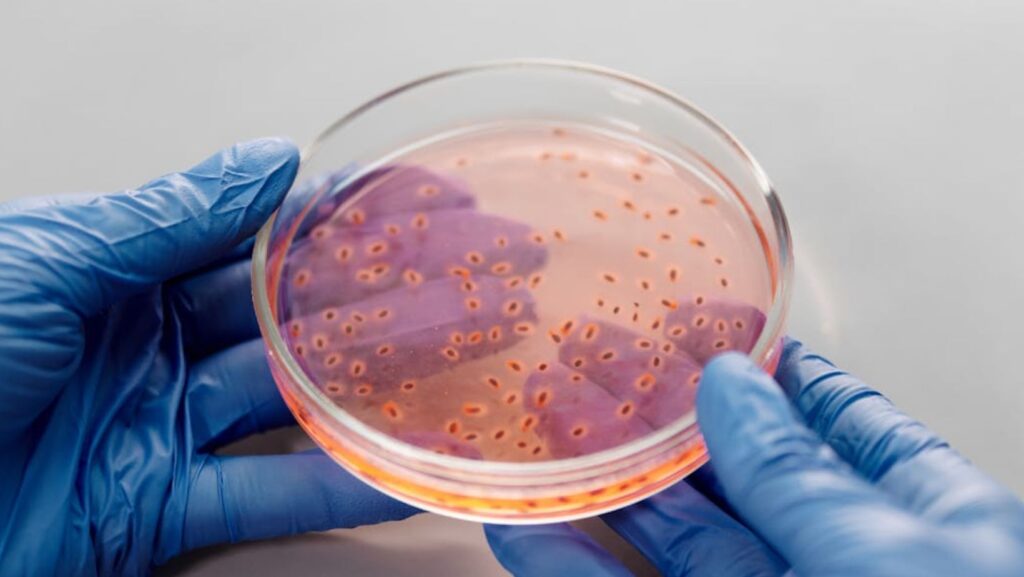

The necessity for precise and efficient analytic methods has become paramount. Advanced plate reader technology has emerged as a key player in this landscape, streamlining a variety of applications, from drug discovery to clinical diagnostics. These sophisticated instruments allow researchers to conduct assays with incredible accuracy and speed, fundamentally changing how experiments are conducted and data are collected.
Understanding Plate Reader Technology
Plate reader technology is integral to modern laboratories, providing rapid measurement of biological samples in multiwell plates. These instruments function by detecting emitted signals from biological or chemical reactions, often fluorescence, absorbance, or luminescence. The evolution of plate readers has seen a shift from traditional methods, which were often time-consuming and prone to variability, to automated systems that provide reliable and reproducible results.
Today’s advanced readers offer improved sensitivity and specificity and feature enhanced software that enables complex data analysis. This level of automation reduces human error, increases throughput, and speeds up the research process considerably, making it important for large-scale studies in genomics, proteomics, and beyond. Consequently, the ability to obtain and analyze data rapidly has transformed how scientific discoveries are made and validated.
High-Throughput Screening Capabilities
High-throughput screening (HTS) is a critical application facilitated by advanced plate readers, allowing researchers to evaluate thousands of compounds quickly. This capability is particularly vital in drug discovery, where large libraries of compounds are screened for potential therapeutic effects. The synergy of robotics and plate reader technology enables unprecedented speeds in experimental setups, reducing the timelines for identifying lead compounds.
With the increased speed and efficiency of HTS, researchers can focus on optimizing hits more effectively. Companies like BMG Labtech provide robust solutions that support these needs, ensuring that scientists can trust their high-throughput data. The efficient processing of data allows for more iterations in drug development, significantly enhancing the chances of successful outcomes in clinical settings. As competitive pressures heighten in pharmaceutical development, leveraging these capabilities has become indispensable.
Application in Clinical Diagnostics
In clinical diagnostics, plate reader technology plays a pivotal role in ensuring accurate patient care. Techniques such as enzyme-linked immunosorbent assay (ELISA) and various types of molecular assays heavily rely on the precise measurements provided by advanced plate readers. These assays have become standard practices for detecting diseases, including cancer and infectious disorders.
The capacity of modern readers to perform multi-parameter analysis simultaneously means that clinicians can obtain comprehensive results in shorter timeframes. This rapid turnaround enhances decision-making processes in patient management, allowing for timely interventions. As a result, the integration of advanced plate readers into clinical laboratories significantly improves healthcare delivery. The continuous evolution of these technologies promises to introduce even more capable systems, potentially revolutionizing the field of diagnostics.
Impact on Research Efficiency and Data Quality
The implementation of advanced plate reader technology contributes to heightened research efficiency and improved data quality. Researchers are inundated with data, making the ability to analyze and interpret results crucial. These advanced systems enhance the speed of data acquisition and improve the consistency and accuracy of results. Sophisticated algorithms assist scientists by enabling richer data analysis and visualization, which aids in identifying trends and patterns that might go unnoticed in traditional methods.
By providing detailed insight into experimental variables, researchers can make informed decisions and refine their hypotheses accordingly. The combination of high-quality data and streamlined workflows leads to more robust conclusions, fostering innovation across various scientific disciplines.
Future Trends in Plate Reader Technology
Looking ahead, the future of plate reader technology appears promising with continual advancements on multiple fronts. Miniaturization and integration with digital laboratory technologies stand out as significant trends. As labs look to optimize their spaces and processes, smaller, more versatile devices will likely gain popularity. The incorporation of artificial intelligence and machine learning in data analysis patterns is set to change the landscape of plate reader technology, providing deeper insights and predictive analytics.
Greater connectivity with laboratory information management systems (LIMS) will allow for even more seamless workflows. These innovations will undoubtedly enhance the capabilities and applications of plate readers, ensuring their continued role as pivotal tools in scientific research and diagnostics. Advanced platforms will address current industry challenges and will open numerous possibilities for future developments, enabling researchers to tackle complex biological questions more effectively.
Adoption Challenges and Solutions
Despite the clear benefits of advanced plate readers, challenges remain regarding their widespread adoption. Many research facilities may face budget constraints and operational hesitations towards integrating new technologies. Training staff to utilize these sophisticated tools effectively can be daunting.
Collaboration between manufacturers and research institutions can address these barriers by providing tailored solutions and training programs. Funding agencies can encourage the adoption of innovative technologies by supporting grants that focus on advanced analytical methods.
The evolution of advanced plate reader technology is undeniably shaping the landscape of scientific research. These instruments significantly boost efficiency, accuracy, and the scope of applications, leading to groundbreaking discoveries in drug development, genomics, and environmental monitoring. As researchers continue to rely on these technologies, ongoing enhancements and innovations will undoubtedly drive further exploration and understanding within the scientific community.


